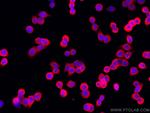
TMEM173/STING Antibody in Immunocytochemistry (ICC/IF)

Search
Proteintech
TMEM173/STING Polyclonal Antibody, CoraLite® 594
{{$productOrderCtrl.translations['antibody.pdp.commerceCard.promotion.promotions']}}
{{$productOrderCtrl.translations['antibody.pdp.commerceCard.promotion.viewpromo']}}
{{$productOrderCtrl.translations['antibody.pdp.commerceCard.promotion.promocode']}}: {{promo.promoCode}} {{promo.promoTitle}} {{promo.promoDescription}}. {{$productOrderCtrl.translations['antibody.pdp.commerceCard.promotion.learnmore']}}
产品信息
CL59419851100UL
种属反应
宿主/亚型
分类
类型
偶联物
激发/发射光谱
形式
浓度
规格
纯化类型
保存液
内含物
保存条件
运输条件
靶标信息
STING is a 379 amino acid containing signaling protein that acts as an important component of innate immune signaling. This signaling protein is able to activate both NF-kappa-B and IRF3 transcription pathways to induce expression of type I interferon (IFN-alpha and IFN-beta) and exert a potent anti-viral state following expression. STING may have translocon function, the translocon possibly being able to influence the induction of type I interferons and is also involved in transduction of apoptotic signals via its association with the major histocompatibility complex class II (MHC-II) thus facilitating the detection of intracellular viral RNA species as well as B-form DNA and mediates death signaling via activation of the extracellular signal-regulated kinase (ERK) pathway. Generally seen in endoplasmic reticulum membrane, cell membrane and mitochondrion outer membrane, it is ubiquitously expressed in most of tissues.
仅用于科研。不用于诊断过程。未经明确授权不得转售。
篇参考文献 (0)
生物信息学
蛋白别名: endoplasmic reticulum IFN stimulator; Endoplasmic reticulum interferon stimulator; ERIS; hMITA; hSTING; Mediator of IRF3 activation; membrane protein; mitochondrial mediator of IRF3 activation; mitochondrial transmembrane protein 173; MMITA; mSTING; N-terminal methionine-proline-tyrosine-serine plasma membrane tetraspanner; rSTING; Stimulator of interferon genes protein; stimulator of interferon protein; stimulator of interferon response cGAMP interactor-deltaC; stimulator of interferon response cGAMP interactor-deltaN; sting 1; STING-deltaC; STING-deltaN; tm173; Transmembrane protein 173; transmembrane protein 173; TMEM173; unnamed protein product
基因别名: 2610307O08Rik; ERIS; hMITA; hSTING; MITA; MPYS; NET23; RGD1562552; SAVI; STING; STING-beta; STING1; TMEM173
UniProt ID: (Human) Q86WV6, (Mouse) Q3TBT3, (Rat) F1M391
Entrez Gene ID: (Human) 340061, (Mouse) 72512, (Rat) 498840